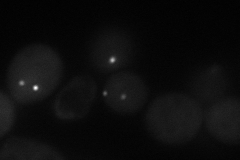
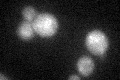

View description
Structural component of the meiotic outer plaque, which is a membrane-organizing center that assembles on the cytoplasmic face of the spindle pole body during meiosis II and triggers the formation of the prospore membrane
Localization:
Intensity:
Fold change:
Significance:
-
C’ GFP library in SD

below threshold15.84 -
N' NOP1pr-GFP in SD
punctate38.6887 -
N' TEF2pr-mCherry in SD

missing0 -
N' NATIVEpr-GFP in SD

punctate16.8723 -
N' TEF2pr-VC and Cyto-VN in SD

#N/A0 -
C’ GFP library in SD+DTT
cytosol15.961No -
C’ GFP library in SD+H2O2

cytosol16.841.06No -
C’ GFP library in Starvation Media

cytosol12.760.8No -
C’ GFP library on the background of Pup2-DaMP

below threshold -
C’ GFP library on the background of CCT mutant

below threshold19.93291.25819No
